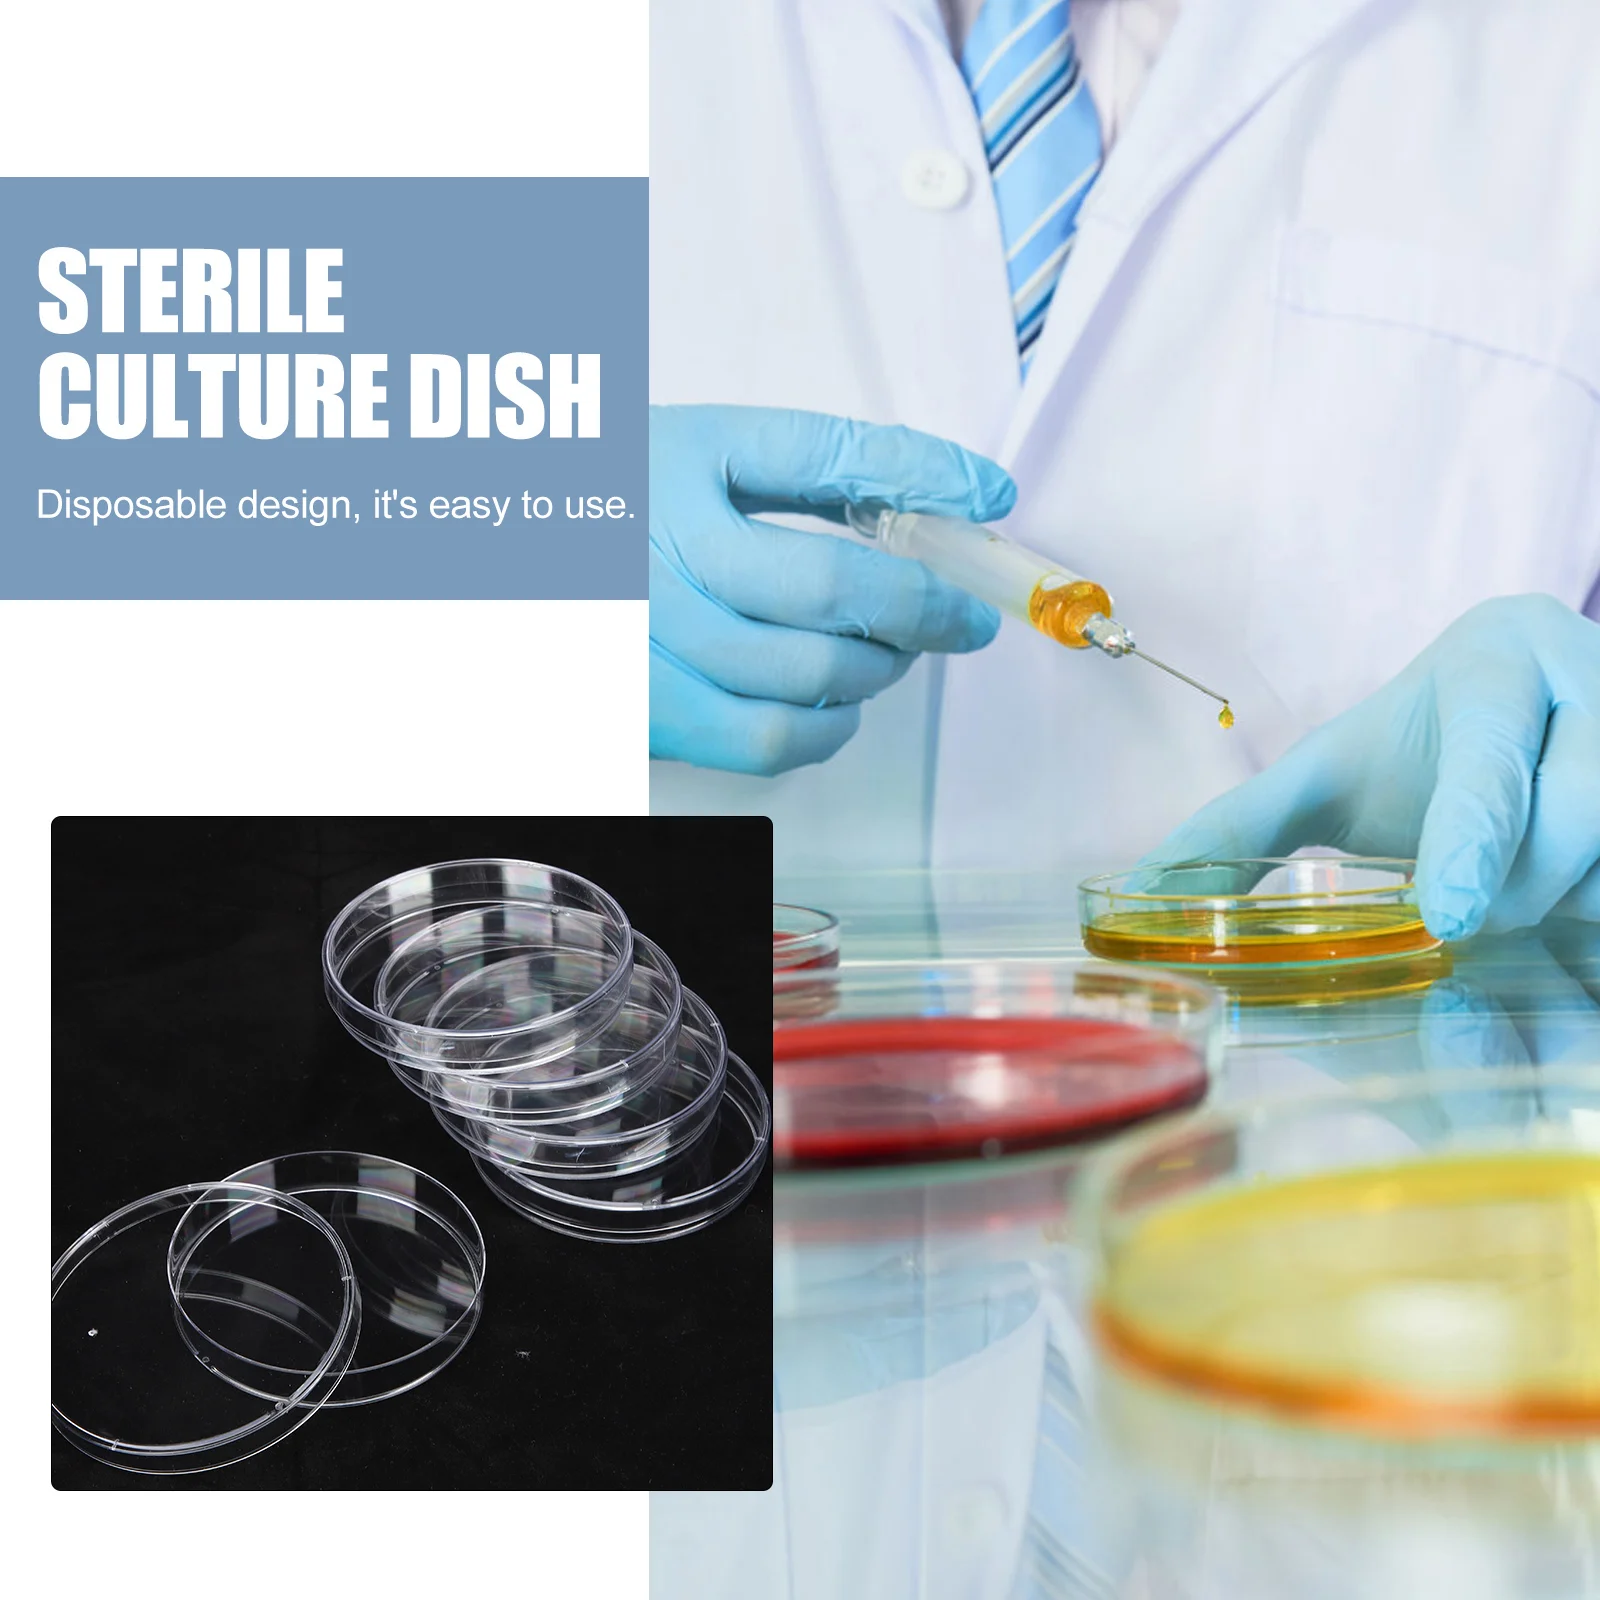
30 Pcs Petri Dish Plates Glass Box Cup Small Equipment Tray Lab Miss Mycology Supplies Dishes Bowl Plastic

Летние новые сандалии 2024 года, кожаные тапочки для мужчин, пляжная обувь для отелей, высокое качество, большой размер 48, легкие туфли на плоской подошве, мужские шлепанцы 38 чёрный
График изменения цены & курс обмена валют
Пользователи также просматривали

1,455.00 руб.
3 пары высококачественных мужских носков, черные спортивные носки, повседневные, мягкие, для бега, всесезонные, впитывающие пот, дышащие, мужские носки One Size
joom.com
2,399.00 руб.
12-дюймовая пластинка STIMULATED DUMMIES - Stimulated All-Stars / Del Meets Th 19391 Stimulated Reco 2001 US Рэп и Хип-хоп/R&B Б/У
joom.com
222.47 руб.
Портативный садовый триммер, точилка, многофункциональное устройство для заточки, скребок, ножницы, кромки, открывание фермы, инструмент для быстрой заточки
aliexpress.ru
671.45 руб.
Петлевая антенна активная Магнитная SDR короткая средняя волна радиоусиление петлевая антенна
aliexpress.ru
5,358.65 руб.
Изысканное и простое дизайнерское жемчужное ожерелье, женское нишевое многослойное универсальное ожерелье в стиле ретро
aliexpress.ru
1,625.23 руб.
Цельный женский купальник, новинка 2024, купальник с V-образным вырезом, сексуальное длинное платье-слинг, монокини, купальный костюм для женщин, Летний Пляжный боди
aliexpress.ru
1,380.92 руб.
Женский Костюм Принцессы Disney, Рапунцель, модель 2024 года, яркое карнавальное платье со стразами, роскошное платье для косплея, день рождения
aliexpress.ru
1,961.77 руб.
Популярный милый школьный портфель Kuromi Melody для подростков, детский красочный рюкзак, школьный портфель для мальчиков и девочек, Вместительная дорожная сумка
aliexpress.ru
8,730.46 руб.
Children BJJ Gis Brazilian Jiu Jitsu Uniforms Kimono TKD Taekwondo Suit Costume For Training and Matches
aliexpress.com
1,266.86 руб.
PGM Men Golf Outdoor sports gloves non slip particles wear resistant ultra fibrous cloth golf golf glove
aliexpress.com
2,125.18 руб.
Женские ботильоны на шнуровке, белые ботинки с круглым носком, низкие сапоги на платформе, в стиле ретро, для лета, 2023
aliexpress.com
427.14 руб.
Guitar Strings Derusting Brush Pen Strings Anti Rust Guitar Cleaner String Care Oil Eraser Guitar Accessories
aliexpress.com
2,831.41 руб.
Original Projector Lamp BL-FU190D for DAXSZUST/GT760/GT760A/W303ST/W305ST/X305ST
aliexpress.com
199.82 руб.
ICOCO 30LED 5V Flexible Safe SMD 5050 RGB Waterproof Light Bar LED Light Strip with Controller for TV Backlight PC Decoration
aliexpress.com
218.42 руб.
Showtly Mom 's love T Shirt Female oversized Women T-shirt Korean Fashion Clothing Streetwear Vogue T-shirts
aliexpress.com
848.62 руб.
For Mercedes Benz W204 C180 C200 C63 Rear Tail Light Plug Socket Tail lamp Cable Connector Wiring Harness
aliexpress.com
3,229.00 руб.
Для Nissan Qashqai J11 2014-2022 BDP1104-1 автомобильный внутренний салон внутренняя ручка открывания двери хромированный пластик левый 80671-4EA0B
joom.ru
836.48 руб.
Деревянная дверная вешалка Hello Seasons, сменный сезонный подвесной знак, знак приветствия для входной двери, подвесной декор для крыльца
aliexpress.ru
866.41 руб.
Современная настольная лампа с USB-зарядкой, прикроватный ночник для спальни, кабинета, гостиной, спальни, офиса, кемпинга, светильник ильник
aliexpress.ru
4,439.66 руб.
Beautiful glass black tea-making utensils ceramic Kungfu tea-making utensils set filter double ear tea-making pots and cups
aliexpress.com
138.33 руб.
Charm Magnifying Glass Necklace Alloy Reading Women Durable Premium Material Long Time Use Fashion Style
aliexpress.com
113.26 руб.
6Pcs Gift Idea Art Brushes Set For Watercolor Acrylic Oil Gouache Painting And Drawing By Professional Artists
aliexpress.com
6,225.06 руб.
ROSES Light Gray فساتين السهرة Round Neckline Long Sleeves Evening Dress with Sparkle Embellishments and Ruched Gown Customized
aliexpress.com
1,289.51 руб.
24 Pcs 150ML Mini Round Containers Dishwasher Microwave Freezer Safe Baby Meal Storage Boxes Plastic Lids Snack Preservation
aliexpress.com
1,851.74 руб.
Applicable For to BMW 3 Series E90 320i 330i M3 2005-2011 Automotive Carbon Fiber Blinds Car Stickers Exterior Accessories
aliexpress.com
19,301.34 руб.
Queen Size Bed Frame with Storage, Bookcase Headboard, RGB LED Lights, Slide Out Side Storage, and Charging Station
aliexpress.com